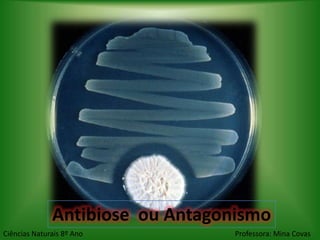
Antibiose ou Antagonismo
Ciências Naturais 8º Ano          Professora: Mina Covas

O documento discute as relações bióticas entre os seres vivos, dividindo-as em intra-específicas e interespecíficas. Detalha os tipos de relações intra-específicas como competição, cooperação e canibalismo. Também descreve as principais relações interespecíficas como mutualismo, parasitismo, comensalismo, predação e antibiose.